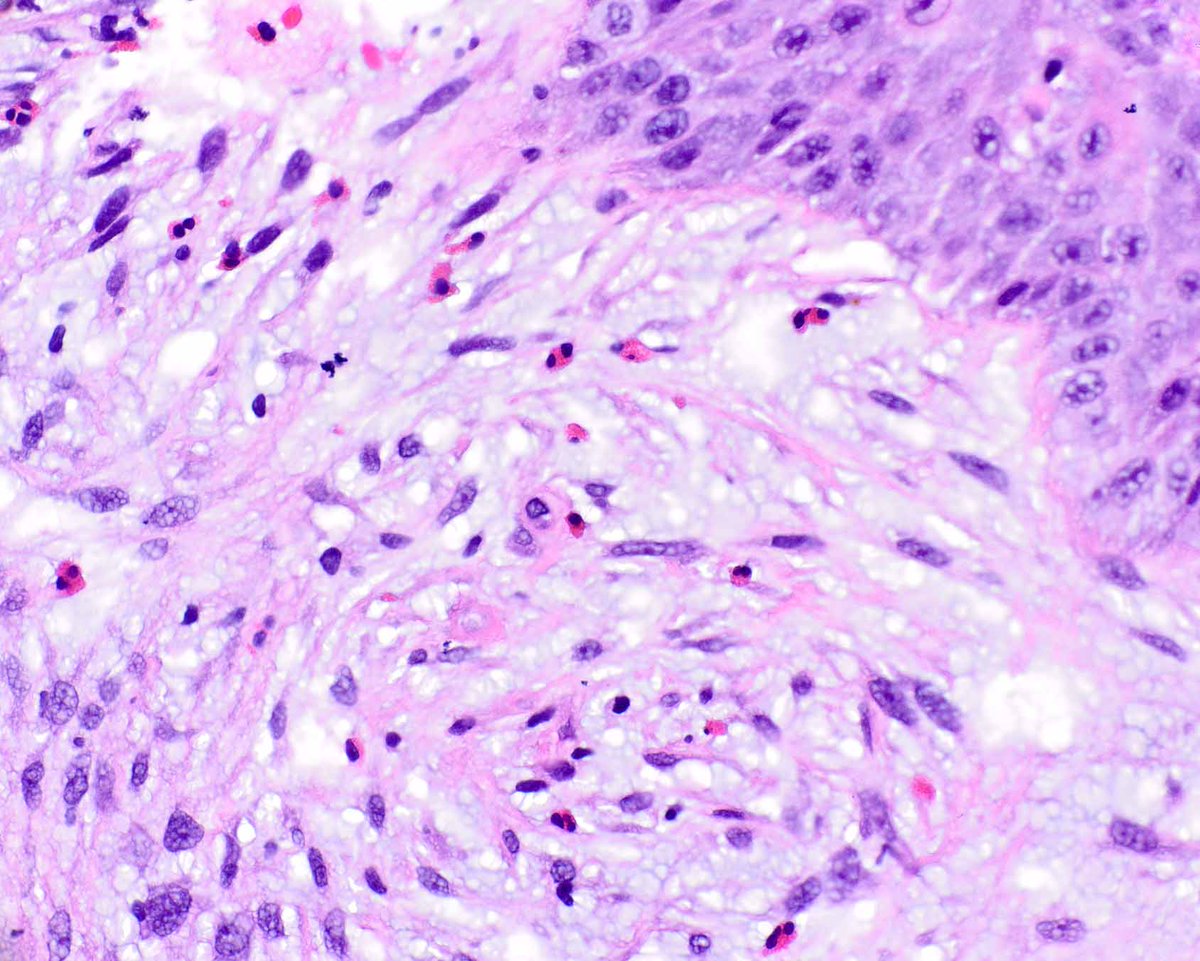
UMiami Pathology tweet media

Sabitlenmiş Tweet

Hi, #PathTwitter, I am Yacob, an AP resident from Ethiopia 🇪🇹, and I am excited to be part of #PathMatch2025.
When I am not diving into pathology 🔬 I enjoy hiking, gardening, and Photography.
Can’t wait to meet future colleagues!
#path2path @Pathologists #pathX #Pathresidents

English